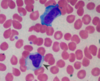
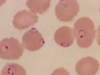

1
Q
Quelles maladies peuvent être engendré par
- coxsackie A 3
- coxsackie B 4
- les deux 2
A
- A
- Herpangine
- Pied, mains, bouches
- Conjonctivite
- B
- Pleurodynie
- Myocardite
- Pericardite
- Cardiomyopathie dilaté
- Ab
- Méningite virale
- Encéphalite
2
Q
Pathogènes responsables diarrhée liquides (8)
A
- liquide
- E.coli
- C. difficile
- C. perfringens
- V. cholerae
- Virus
- rota-
- neuro-
- adéno-
- Protozoaires
3
Q
Pathogènes responsables diarrhée sangulantes (7)
A
- sangulante
- E.coli
- entéro-invasif
- entérohémorragique
- C. jujeni
- Salmonelle non thypoide
- Shigelle
- Yersinia enterocolitica
- Protozoaires
- E.coli
4
Q
- Diarrhée inflammatoire → lésions de ? + selles (3)
- Diarrhée grasse
- Malabsorbtion → lésions de ?
- Maldigestion → lésions ? malabsorption de (5)
- Diarrhée liquides
- sécrétoire
- osmotique
- fonctionnel
A
- Lésions muqueuse intestinale → hypersécrétion d’eau induite par cytokines, altérer l’absorption
→ Mucus, sang et leucocytes présents dans selles. - Altérations muqueuse intestinale → mauvaise absorption des aliments digérés
- Manque d’enzymes digestives → altération dégradation des aliments
→ malabsorption glucides, protéines, lipides, vit liposolubles (A, D, E, K) et B 12
- Manque d’enzymes digestives → altération dégradation des aliments
- Altérations muqueuse intestinale → mauvaise absorption des aliments digérés
-
- Sécrétion active d’eau via inhibition ou activation d’enzymes (↑ activité AMPc )
- Mauvaise absorption ou ingestion excessive hydrophiles → aspiration d’eau dans lumière
- Passage intestinal rapide
5
Q
Diarrhée
Clinique
- Durée
- Diarrhée aiguë
- Diarrhée persistante
- Diarrhée chronique
- Types de selles (3)
- Autres symptômes (5)
A
- Durée
- ≤ 14 jours
- 15–30 jours
- > 30 jours
- aqueuses, grasses ou sanglantes
- Symptômes associés
- Fièvre
- Douleur abdominale
- N/V
- Déshydratation
- Cas chroniques : malnutrition et, chez les enfants, retard de croissance
6
Q
Diarrhée
Diagnostic
- sur les selles on va vouloir voir/faire quoi ?
- Calcule
- faible → donner chiffre
- haut → donner chiffre
A
- Coproculture → infectieux
- Ecart osmotique des selles
- Faible < 50mmol/l = sécrétoire ou fonctionnelle
- Infections alimentaire
- Tumeurs endocrines
- Absorption altérée des acides biliaires et/ou des sels
- Elevée ≥ 100mmol/l = osmotique
- Ingestion de laxatifs osmotiques
- Malabsorption
- Insuffisance pancréatique
- Faible < 50mmol/l = sécrétoire ou fonctionnelle
7
Q
Diarrhée
PEC / TTT
- Attention à quoi dans diarrhée ? (2)
- Diarrhée aigue
- Pharma (1)
A
- attention
- Acidose métabolique sans trou anionique augmenté → perte de liquide riche en bicarbonate
- Déshydratation
- légère à modérée → réhydratation orale
- Cas sévères → réanimation liquidienne IV
± Envisagez l’hospitalisation.
- Diarrhée aiguë généralement infection virale spontanément résolutive, soutien .
- Antidiarrhéiques
- Lopéramide → Agoniste rcp opioïdes → augmente temps transit intestinal
- Meilleur TTT initial → diarrhée par chimiothérapie
- éviter si fébrile ou selles sanglantes
- Lopéramide → Agoniste rcp opioïdes → augmente temps transit intestinal
8
Q
Lymphogranulome vénérien
- Pathogène
- Épidémiologie
- Caractéristiques cliniques
- Primo → 2
- Secondaire → 3
- TTT 1
A
- Pathogène : Chlamydia trachomatis sérotypes L1–L3
- Épidémiologie
- Augmentation chez les homosexuels
- Caractéristiques cliniques
- primo-infection → petits ulcères génitaux indolores ( herpétiformes ) → guérissent spontanément en quelques jours
- Infection secondaire → gonflement douloureux des ganglions lymphatiques de la région inguinale avec formation d’ abcès ( écoulement de pus )
- Traitement : doxycycline
9
Q
Neisseria gonorrhoeae chez NN quoi comme clinique ?
- Clinique 3 ± 2
- Manifestation quand ?
A
- Clinique
- conjonctivite néonatale
- pertes oculaires épaisses et purulentes
- gonflement prononcé des paupières
- ± infection gonococcique disséminée et une arthrite septique
- Chez les NN 2 à 7 jours pp
10
Q
Chlamydia trachomatis chez NN quoi comme clinique ?
- Clinique n°1 → 3
- Manifestation quand ?
- Clinique n°2 → 3
- Manifestation quand ?
A
- Clinique
- conjonctivite néonatale
- écoulement oculaire mucopurulent
- gonflement de ce patient.
- 5 à 14 jours pp
- Clinique 2
- syndrome de pneumonie afébrile
- toux saccadée
- signes de pneumonie interstitielle à la Rx
- à 1 à 3 mois pp
11
Q
Borreliose
- Pathogène + vecteur
- 4 Stades et le temps
- 1
- 4
- 3
A
- Pathogène = Borrelia burgdorferi → spirochète
= Vecteur → tique - Stades :
- Stade 0 → attachement ≥12-24h
- Stade I → 7 à 14j = Érythème chronique migrant
- Stade II → 1 - 6mois =
- Arthralgies migratoires
- Neuroborréliose précoce +++ nerf facial
- Cardite de Lyme
- Lésions multiples d’érythème migrant
- Stade III → années
- Arthrite de Lyme chronique
- Neuroborréliose tardive :
- Méningite aseptique
- Encéphalomyélite progressive

12
Q
Borreliose
- Diagnostic
- TTT 1 + 1 si Grossesse/Allaitement ou patient ped
- Hospit et IV à partir quel stade ?
A
- Clinique !
→ sérologie Borrelia négative à ce stade
En cas de doute mesurer lésion et revoir le patient à quelques jours - Traitement:
- Doxycycline 100mg x2/j 14j
- Si G/A ou patient ped → Amoxicilline 1g 3x/j 14j
- Stade 2 →

13
Q
Fièvre thypoïde
- Germe
- Incubation
- Progression
- 2
- 4
- 2
A
- Salmonella enterica sérotype Typhi : fièvre typhoïde
- 5-30jours
- Semaine 1
- Bradycardie relative
- Constipation ou diarrhée
- Semaine 2
- Fièvre persistante
- Taches roses ; exanthème de couleur rose bas de la poitrine et l’abdomen
- Diarrhée jaune-verte / occlusion intestinale (plaques de Peyer enflées)
- Symptômes neurologiques ( délire , coma )
- Semaine 3
- Ulcération gastro-intestinale avec saignement et perforation
- Hépatosplénomégalie
- Semaine 1

14
Q
Fièvre thypoïde
- Diagnostic 2
- TTT 2
- Complication 1
- Prévention 1
A
- a. Hémocultures : La bactériémie est détectable à partir de la semaine 1 de la maladie.
b. Cultures de selles - a. 1er intention : fluoroquinolones ( ciprofloxacine )
b. céphalosporines 3e G → si infection sévère - R cancer VB
- Vaccin
15
Q
Influenza
- Type et infecte qui ?
- Physiopatho
- Clinique 7
A
- Influenza A → animaux et humains et B → humains
- Mutation
- Changement antigénique → réassortiment → nv sous-type
- Mutation ponctuelle
- Clinique
- Apparition soudaine forte fièvre
- Frissons
- Céphalées
- Arthralgie
- Myalgie
- Fatigue
- Bronchite aiguë + toux
16
Q
Influenza
- Examen pour diagnostic
- TTT
- soutient 3
- pharma 2
indication 3 + 2
A
- Études de confirmation
- RT-PCR
- Test antigénique rapide → antigènes → Haute spécificité
- TTT
- Soutient :
- Réhydratation orale
- Antipyrétiques et analgésiques oraux
- Antitussifs pour soulager la toux sèche
- Pharmaco si grippe suspectée ou documentée et ≥ 1 des éléments suivants :
- Maladie grave ou évolutive
- Hospitalisation requise
- Risque élevé de complications de la grippe
et ≥ 1 des éléments :- Début ≤ 48 heures
- Contact étroit avec des patients à haut risque
- Inhibiteurs de la neuraminidase → inhibe libération virus de la ¢ hôte
→ Oseltamivir oral
→ Zanamivir inhalé
- Soutient :
17
Q
Influenza
- Patients à risque ? 6
- Complications 4
A
- Patients:
- Adultes ≥ 65 ans
- Enfants de < 5 ans, ++ < 2 ans
- Patientes enceintes → R ⇡ acc prématuré et avortement + malfo, RCIU
- asthme, diabète sucré, immunosuppression
- Compli
- Pneumonie grippale primaire → Pneumonie hémorragique
- Bronchite bactérienne secondaire et pneumonie
- *→** toux purulente et productive après amélioration
- IVRS
- OMA
- Sinusite
18
Q
Herpès
- virus dormant où ? pour HSV1 et HSV2
- HSV1
- prodromique 3 cmb de tmp
- lésion 2
- HSV2
- clinique 5 + 1
- Lésion 2
A
- virus reste dormant dans les neurones ganglionnaires
- Ganglion trijumeau : HSV-1
- Ganglion sacré : HSV -2
- HSV1 :
- Symptômes prodromiques ∼ 24 h: douleurs , picotements, brûlures
- Vésicules érythémateuses → transforment en ulcérations douloureuses
- HSV2
- Organes génitaux : rougeur, gonflement, picotements, douleur, prurit
- Lymphadénopathie région de l’aine
- Après plusieurs jours → lésions à l’emporte-pièce → s’ulcèrent

19
Q
Herpès
Gingivostomatite HSV1
- Patients touchés 2
- Clinique 4
Vulvovaginite aigue HSV2
A
- +++ enfant 1-6ans, immunosupp
- C
- Fièvre
- Dysphagie
- Hypersialorrhée
- Adénopathie

20
Q
Herpès
Forme particulière 3
A
- Panaris herpétiques
- Herpès cutané chronique → lors immunosupp
- Eczéma herpétique ou Pustulose varioliforme de kaposi-Juliusberg
- Avec dermatite atopique pré-existante

21
Q
Herpès
Diagnostic 6
A
- Principalement → caractéristiques cliniques
- PCR → l’ADN du HSV GS!!!
- Immunofluorescence directe
- Sérologie ø valeur si primo inf
IgM 10j et IgG 15j - Culture virale
- Microscopie optique sur frottis de Tzanck → ne fait plus
22
Q
Herpès
TTT
effet 2
Agents 2 + 2
A
- Effet
→ ⇣ durée et gravité de l’infection
→ plus efficace si initié dans les 72 heures - Agents
- Première ligne : acyclovir oral
- Si HSV-1 résistant à l’acyclovir ou immunodep : foscarnet
- Valacyclovir
- Famciclovir
23
Q
CMV
1.
A
- Transfusions sanguines
- Transmission sexuelle
- transplacentaire
- Transmission périnatale
- Liquides corporels (p. ex., gouttelettes respiratoires, salive, urine, sécrétions génitales)
- Infection transmise par greffe (p. ex., moelle osseuse , poumons ,reins )
*
- Transfusions sanguines
24
Q
CMV
Clinique
- ImmunoOK 10
A
- > 90% asymptomatique
- < 10% Mononucléose à CMV
- Fièvre
- Myalgie / arthralgie
- Fatigue
- Céphalées
- Dysphagie
- Lymphadénopathie cervicale
- Hépatomégalie/Splénomégalie
- DDx → EBV mais test d’anticorps hétérophiles serait négatif
25
**_CMV_**
Clinique
1. Immuno pas OK 5
1. clinique
2. examen
1. **Pneumonie à CMV** : pneumonie interstitielle **Ag pp65**
1. fièvre, toux, dyspnée
2. Rx → infiltrats interstitiels bilatéraux diffus + CMV liquide bronchoalvéolaire
2. **Rétinite à CMV** :
1. corps flottants, photopsie, défauts du champ visuel
2. **Fundoscopie**
3. **Oesophagite à CMV** et/ou **colite à CMV**
1. odynophagie, douleurs abdominales, diarrhée sanglante
2. Examen endoscopique → **ulcères** **linéaires**
4. **Insuffisance surrénalienne**
5. **Encéphalite à CMV** : altération des fonctions cognitives, déficits neurologiques
26
**_CMV_**
## Footnote
Diagnostic 6
1. **CBC** : lymphocytose **\> 10% de lymphocytes atypiques**
2. **Biopsie** **tissulaire** : gros lymphocytes atypiques à corps d'inclusion intranucléaires en forme **d'œil de chouette**
3. **Test Monospot :** Ac hétérophiles → négatif vs + pour EBV
4. **Tests sérologiques**
5. **PCR** dans les fluides corporels
6. **Fundoscopie** → **hémorragies** rétiniennes et **taches** **cotonneuses** *aspect « pizza »*

27
**_CMV_**
TTT 6
1. Rétinite 3
2. Oesophagite et Colite 2
3. Pneumonie 3
4. Encéphalite 2
1. Rétinite à CMV
1. **Valganciclovir 3-6mois**
2. **si proche** fovéa : ajoute injections intravitréennes de ganciclovir ou foscarnet
2. Oesophagite et Colite
* **valganciclovir oral 21-42j**
* grave : ganciclovir IV ou foscarnet IV
3. Pneumonie
1. **ganciclovir** IV ou foscarnet IV et **immunoglobuline** IV
4. Encéphalite
1. **ganciclovir** et **foscarnet** **IV**
28
**_Mononucléose_**
1. Germe
2. Comment infecte ?
3. durée symptômes ?
4. Clinique
1. EBV → maladie du bisous
2. EBV infecte → LB via CD21 rcp → CD8 LT fight back
3. 2-4semaines
4. **C**
1. **Hépatomégalie/Splénomégalie**
2. T°, fatigue, malaise
3. **Pharyngite** et/ou **tonsillite**
4. **Lymphadénopathie** cervicale (++ postérieure)
5. **Eruption maculopapuleuse →** + du au pénicillines
29
**_Mononucléose_**
1. Diagnostic 2
2. TTT/préventions 3
3. Complications 8
1. D
1. Test rapide sang détecte Ac → agglutination Sp100% et Sn 85%
2. Sang sur lame → L atypique
2. → éviter sport R rupture rate
Analgésiques/Antipyrétique
ø ATB → svt confondu avec angine
3. complications
* Anémie hémolytique AI, thrombocytopénie
* Obstruction des VRS
* Rupture splénique
* Leucoplasie orale
* **Malignités associées**
* Lymphome de Burkitt = L non hodgkinien
* lymphome de Hodgkin
* **Carcinome du nasopharynx**
* Trouble lymphoprolifératif → réactivation de l' EBV lors immunodef
30
**_SIDA_**
1. definition
2. Pathologies que l'on retrouve ? 3
1. défini par un nombre de CD4 **\< 200 cellules/μL**
2. **Pathologies**
1. lymphomes non hodgkiniens
2. Propagation rapide d'infections bactériennes et fongiques opportunistes et non opportunistes
→ toxoplasmose cérébrale
→ candidose
3. Réactivation d'infections latentes ( tuberculose, infections à HSV, zona)
→ CMV
31
**_Malaria_**
1. **Pathogène**?
2. **Vecteur**
3. **Résistance partielle contre le paludisme**
4. SS type
1. bénin 3 + T° toute les ?
2. forme grave 1
1. **Pathogène** :*Plasmodia*
2. **Vecteur** : le moustique *Anopheles* **femelle**
3. Porteurs de la mutation **drépanocytaire**
4. SS type
1. vivax 48h
ovale 48h
malariae 72h T°
2. falciparum irrégulier

32
**_Malaria_**
1. Incubation ?
2. Clinique
1. générale 3
2. systèmes atteints
1. 2
2. 1
3. Grave
1. **7 à 30j**
2. C
1. Symptômes pseudo-grippaux
maux de tête
Forte fièvre
2. Sang
1. **Thrombocytopénie** : risque hémorragique accru
2. **Anémie** **hémolytique** : faiblesse, pâleur, vertiges
3. **Foie** : hépato-splénomégalie ,ictère discret
4. Erythrocytes infectés obstruent capillaires, ± entraîner dysfonctionnement sévère organes
1. *Rein : oligurie, **hémoglobinurie**, IRA*
2. *Cérébral : **hallucinations**, confusion, trbl EC, convulsions*
3. *Cardiopulmonaire : **IC**, œdème pulmonaire , SDRA , choc*

33
**_Malaria_**
1. Diagnostic
1. 2
2. 3
1. **FSC**
1. Anémie hémolytique : ↓ Hb,↓ haptoglobine ,↑ LDH ,↑ bilirubine indirecte ,↑ réticulocytes
2. Thrombocytopénie
2. **Frottis de sang**
1. → visualisation parasites dans GR
2. **Meilleur test initial** : **frottis sanguin épais** → Sn haute
3. **Test de confirmation** : **frottis sanguin fin**
Sn + faible, mais Sp + élevée
34
**_Malaria_**
TTT
Lequel ok pour grossesse
1. Traitement et prophylaxie du paludisme dû à *Plasmodium malariae* , *Plasmodium ovale* ou *Plasmodium vivax*
1. ES 3
2. Paludisme à falciparum non compliqué R à la chloroquine 2
1. ES 2
3. Paludisme grave à falciparum 1
1. ES 1
1. Chloroquine → OK pour Grossesse → si préventif Méfloquine
* **ø préventif pour P. flaciparum !!!***
1. photosensibilité
2. Rétinopathie
3. Gêne gastro
2. Atovaquone-proguanil
1. Gêne gastro
2. rare IH / anémie
3. Artésunat
1. crise hémolytique si déficit G6PD

35
**_Toxoplasma gondi_**
1. Type de germe
2. Transmission 3
1. Protozoaire uni¢ intra¢ obligatoire
2. Voie de transmission
1. Ingestion orale → oocystes
1. Excréments de chat
2. Viande crue ou insuffisamment cuite (la plus courante)
3. Lait non pasteurisé (en particulier lait de chèvre )
2. Transplacentaire
3. transplantation d'organe ou transfusion sanguine
36
**_Toxoplasma gondi_**
Clinique
1. immunocompétents 2
2. immunocompétents 2
1. Patients immunocompétents
1. Principalement asymptomatique
2. Symptomatique \<10% → symptômes de type mononucléose avec adénopathie cervicale bilatérale ( **Ac hétérophiles négatif** )
2. Patients immunodéprimés (p. ex., SIDA ) : primo-infection ou réactivation
1. Toxoplasmose **cérébrale** ( +++ courante lors du SIDA )
* *anneaux multiples** → ggl base
2. Toxoplasmose **oculaire**
* *choriorétinite**
37
**_Toxoplasma gondi_**
## Footnote
Diagnostic 2
1. **Sérologie**
1. Test d'anticorps IgM
2. test d'anticorps **IgG** ;reste positif pour la vie
2. **TDM/ IRM** :du cerveau en cas de suspicion de toxoplasmose cérébrale
38
**_Toxoplasma gondi_**
TTT
1. indication (2)
2. ttt (4)
1. Indications :
1. Immunosuppression (p. ex., VIH )
2. Femmes enceintes infectées
2. TTT
1. Premier choix → Spiramycine si infection maternelle avant la 18 ème semaine
2. pyriméthamine, sulfadiazine et leucovorine (acide folinique)
39
Vers ronds
## Footnote
Transmis par (4)
1. fecal-oral
2. Viande pas bien cuites ++ porc
3. Par la peau via larve
4. Par morsure mouche
40
Vers plats = trematodes
## Footnote
Infectent quels systèmes (4)
1. vaisseaux
2. appareil digestif
3. poumons
4. foie
41
Vers plats = trematodes
## Footnote
Diagnostic via ? (1)
TTT majoritaire ? (2)
Diag → oeufs dans selles
Praziguantel
Triclabendazole
42
Vers plats = cestodes
1. Maladies
2. TTT majoritaire ? (2)
1. Teniase
Diphyllobothriase
Echinococcose
Hyménolépisie
2. Praziquantel
Albendazole


